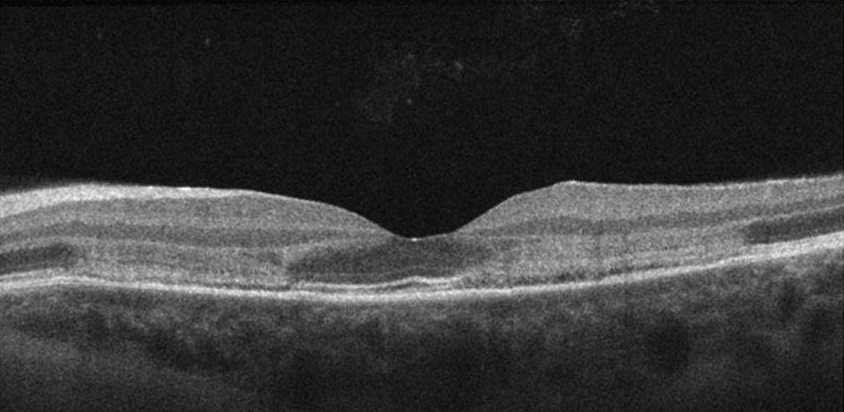

Acute Macular Neuroretinopathy (AMN)

Close
- Acute Macular Neuroretinopathy (AMN) is a rare microischemic event affecting outer retina and choriocappilaris that presents with an acute onset of centra/paracentral scotomas and/or decreased vision. It is most commonly seen in young females in their 3rd decade of life and is typically bilateral.
- More information at Eyewiki page
-
AMN in 22 year old female that presented with bilateral paracentral scotomas and blurry vision. Presenting BCVA was 20/20 OD and 20/25 OS.
Right eye:

Left eye:
Right eye Optos photo:

Left eye Optos photo:

